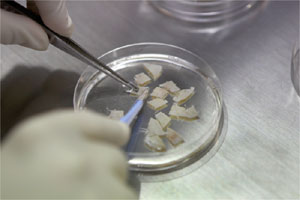
newtech130204

至少八成女性癌症患者在接受化疗或电疗后,卵巢功能会衰竭或提前进入更年期,影响生育能力。本地医生首次利用新技术,成功让一名女病人重获生育能力。
这项具突破性的新技术名为卵巢原位移植手术(Ovarian Orthotopic Transplant),医生在病人化疗前,先切取病人一部分不受癌细胞影响的健康卵巢组织,在约摄氏零下200度的环境中冷冻。病人完成化疗的两年至五年后,如果身体健康稳定,医生可把冷冻卵巢组织重新植入卵巢,让它自行生长,修复卵巢功能。
新加坡中央医院去年8月完成了本地第一宗卵巢原位移植手术。成功接受手术的陈姓妇女(40岁,客服人员),在术后三个月左右开始有月经,恢复了生育能力。
陈姓妇女受访时说:“2009年底我被诊断患有初期乳癌,但我和丈夫一直希望能有自己的小孩,所以听了医生的讲解后决定冷冻卵巢组织。手术后三个月我的月经来了,现在感觉一切都很正常,能不能怀孕就顺其自然吧。”
中央医院生育辅助学组长兼高级顾问医生余素玲日前在记者会上说:“整个移植手术从解冻到移植需要一个多小时。在手术时,医生把一片片已解冻的卵巢组织塞入病人体内已受损的卵巢中,缝合切口后让组织重新生长,恢复血液供应。”
较适合18岁至40岁女性
手术最终目的是帮助女性癌症患者修复卵巢功能,但并不是每名患者都适用。余素玲解释道,理想病人的年龄一般介于18岁至40岁,女性在40岁之前仍拥有较正常的卵子数量。
初期癌症患者,特别是患上较不会影响卵巢的癌症如乳癌和霍奇金氏淋巴瘤(Hodgkin’s lymphoma)等的病人,能进行这项手术的机会较大,不过医生必须先确保卵巢组织不被癌细胞影响。
中央医院早在2008年已推出卵巢组织冷冻保存的技术,至今已为13名年龄介于19岁至40岁的女性癌症患者冷冻卵巢组织,但目前本地只有一人接受移植手术。余素玲直言,虽然目前还无法了解手术的长期效果,但移植技术将在很大程度上帮助女性癌症患者完成生育梦想。
她说:“卵巢组织可被冷冻保存长达10年,如果在40岁时冷冻卵巢,化疗五年后再移植,届时卵巢功能却仍停留在40岁,还很‘年轻’,因此对希望生育的患癌女性是一大帮助。”
该院妇产科高级顾问医生陈学崐副教授则说,近年来本地患癌女性有年轻化趋势,在成功对抗癌症的同时,她们不应该失去生儿育女的权利。
切取卵巢的费用介于1600元至4000元,移植卵巢的费用则介于1800元至5500元,两项手术费用都能以保健储蓄(Medisave)支付。但病人得另付4000元来冷冻、储存和解冻卵巢组织。
卵巢组织可被冷冻保存长达10年,如果在40岁时冷冻卵巢,化疗五年后再移植,届时卵巢功能却仍停留在40岁,还很“年轻”,因此对希望生育的患癌女性是一大帮助。——中央医院生育辅助学组长兼高级顾问医生余素玲